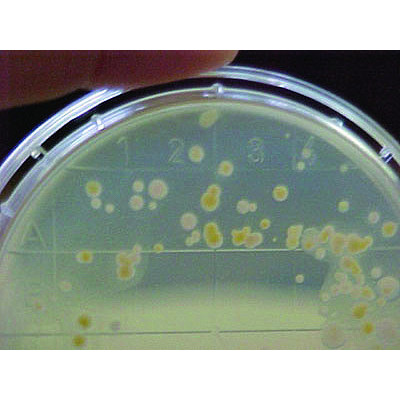
AGAR HEKTOEN 10 placas
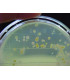
AGAR HEKTOEN 10 placas

Contacto - 91 005 91 70 / 91 776 87 11 - info@ibdciencia.com - Pide tu presupuesto
AGAR HEKTOEN 10 placas
Placa 90mm 20 und. Agar entérico
37,01 €
(iva inc.)
Referencia:
PQ3033